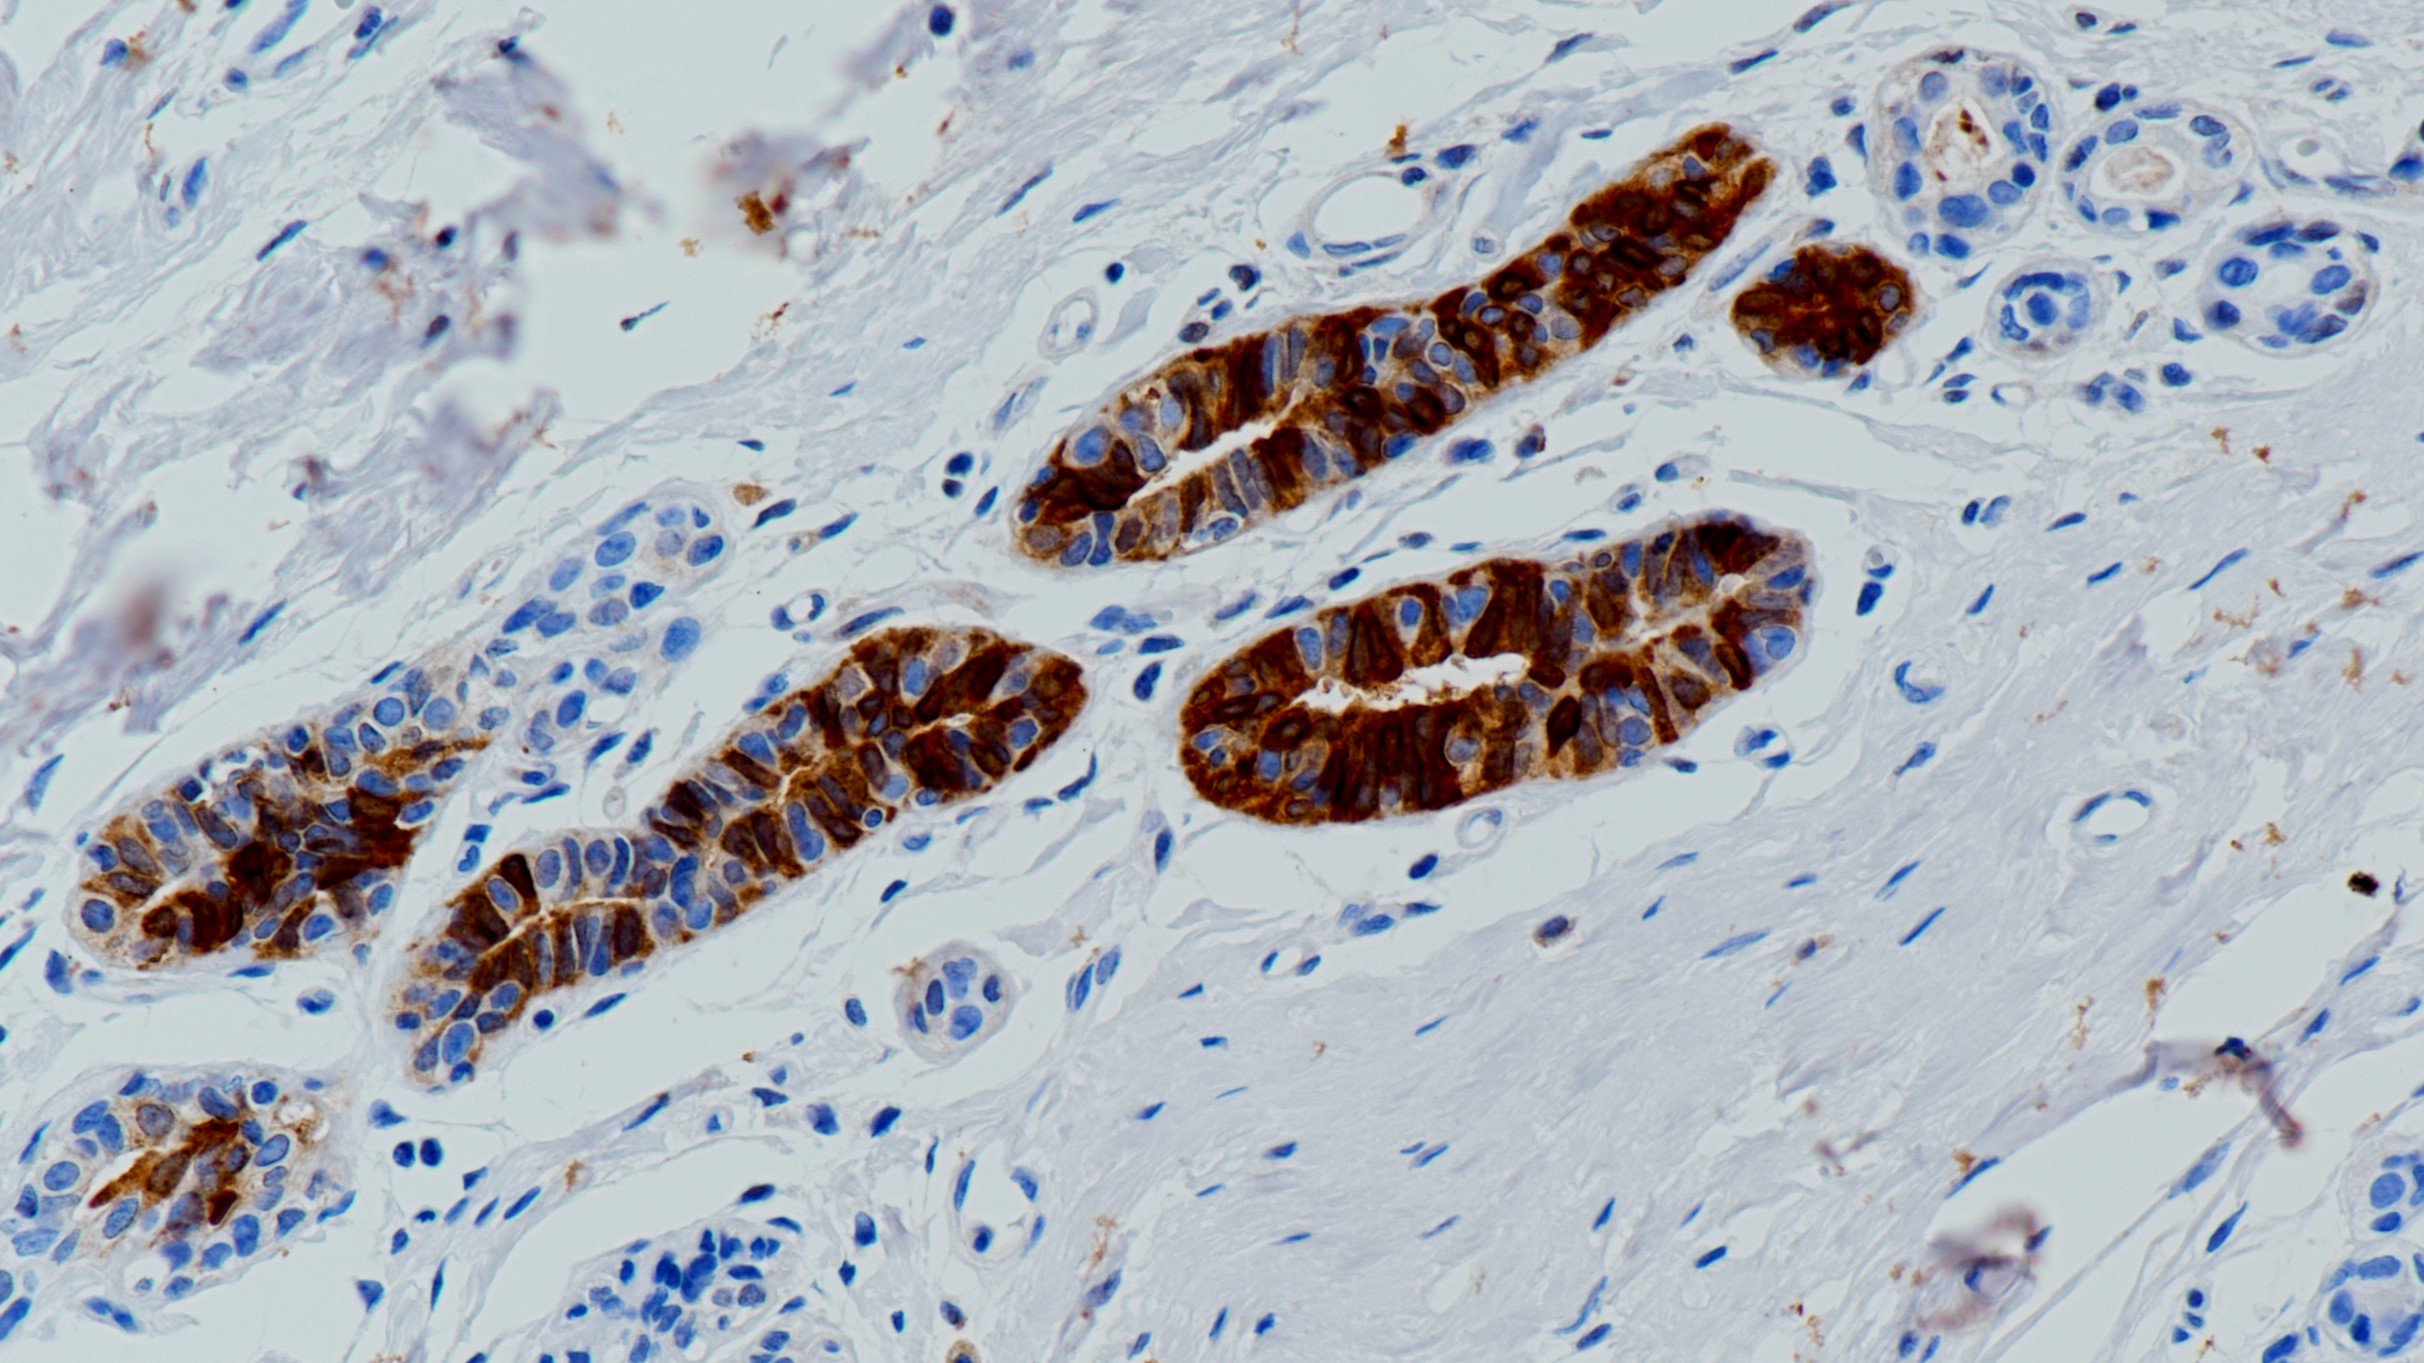
乳腺Mammaglobin(BP6125)染色.jpg

1. Leygue E, Snell L, Dotzlaw H, et al. Mammaglobin, a potential marker of breast cancer nodal metastasis.[J]. Journal of Pathology, 2015, 189(1):28-33.
2. The Breast, 2010, 19(5):355-359. 9.6 Fleming T P, Watson M A. Mammaglobin, a breast-specific gene, and its utility as a marker for breast cancer.[J]. Annals of the New York Academy of Sciences, 2010, 923(1):78-79.